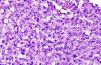
fig0010

Leishmaniasis is a parasitic disease caused by protozoan species of the genus Leishmania. Its geographical distribution can be divided into 2 general areas; the New World (Mexico, Central America and South America) and the Old World (Asia, Africa and Southern Europe).1 The clinical spectrum depends on the pathogenicity of the Leishmania species and the immune response of the host.2 Cutaneous leishmaniasis (CL) is the most common and mildest clinical form, accounting for between 50% and 75% of cases.1,2 Atrial involvement is very rare; only a few cases have been described in the Old World, none of which exclusively affected the ear lobe. We report 2 cases of CL with ear lobe involvement (Fig. 1, A and B).
A 73-year-old woman presented with a painful lesion on the pinna that had developed 7 months previously. Physical examination revealed an erythematous infiltrated plaque with central ulceration and a seropurulent crust on the left ear lobe and coalescing pustules on the antihelix (Fig. 1A). Leishmania species was visualized by Giemsa staining of the biopsy imprint. Histopathology revealed the presence of intracytoplasmic basophilic punctate structures within histiocytes that were compatible with amastigotes (Fig. 2). Intramuscular meglumine antimoniate (MA; 60mg/kg/d) was administered for 12 days; this regimen was repeated 2 weeks later, followed by cryotherapy of the residual lesion, resulting in cure.
Histopathology: skin with dense inflammatory infiltrate (lymphocytes, histiocytes, and plasma cells) occupying the entire dermis. Basophilic punctate structures (arrow) corresponding to Leishmania species can be seen in the cytoplasm of the histiocytes (Giemsa staining, original magnification ×40).
An 86-year-old man presented with a painful lesion on the ear lobe of 4 months’ duration. Examination revealed soft edema and hyperemic nodular infiltration of the right ear lobe (Fig. 1B). Direct smear revealed the presence of Leishmania amastigotes. Promastigote forms of Leishmania grew in culture within a few days, and were characterized as Leishmania infantum by polymerase chain reaction with enzyme-linked immunosorbent assay. Histological analysis of an infiltrated margin showed collections of histiocytes and the presence of Leishmania bodies. The patient was treated with 2 intralesional injections of MA separated by 15 days. Cure of the lesion was achieved 2 months after completion of the treatment.
CL has an incidence of 1.5 million new cases per year.3,4 The vast majority of cases (90%) occur in 7 countries: Afghanistan, Saudi Arabia, Iran, Iraq, Algeria, Pakistan, and Peru.4 In Spain the disease is considered hypoendemic (mainly affecting the Mediterranean coast, Castile and León, and Aragón); its incidence (0.4 cases per 100 000 inhabitants per year) is increasing due to migration, environmental changes, and the development of immunosuppressive conditions.5
In the Old World the clinical presentation of CL is known as oriental sore. A single lesion develops in 58% to 70% of patients. Lesions are usually located in exposed areas, such as the upper extremities (40%-45%), head and neck (18%-37%), and lower extremities (6%-23%).1,3 Ear lobe involvement is typical in cases from southeastern Mexico and Central America (chiclero ulcer), and is usually caused by Leishmania mexicana complex, which accounts for 5% of all CL cases.1,4,6 Involvement of the ear lobe is very rare in cases of Old World leishmaniasis, as summarized in Table 1.
Cases of Leishmaniasis With Ear Lobe Involvement Described in the Old World.
| Authors | Year | Country | Age, y | Sex | Prior Medical History | Location | Time Since Onset, mo | Treatment |
| Skevas et al.7 | 1997 | Albania | 32 | M | Immunocompetent | Left pinna | 16 | MA, 60mg/kg/d IM for 20 d |
| Martinelli et al.8 | 2005 | Italy | 66 | M | Immunocompetent | Right helix | 12 | MA, 60 mg/kg/d IM for 15 d; 2 cycles 15 d apart |
| Fagundo Gonzalez et al.3 | 2005 | Spain | 48 | F | Immunocompetent | Right helix and antihelix | 2 | MA, 1.5g/d IM for 2wk; 3 cycles, each 15 d apart |
| Quante et al.9 | 2006 | Cyprus | - | M | Immunocompetent | Entire pinna | - | - |
| Van Der Vliet et al.10 | 2006 | France | 28 | M | Immunocompetent | Right helix | 2 | MA, 20mg/kg/d IM for 13 d plus 2 intralesional injections |
| Khorsandi Ashtiani et al.4 | 2008 | Iran | 42 | M | Diabetes mellitus, hypertension | Entire pinna, left ear | 2 | MA, 20mg/kg/d IM for 3wk; 2 cycles 3wk apart |
| Sabri et al.1 | 2009 | Syria | 73 | M | Immunocompetent | Left helix | 2 | - |
| Robati et al.2 | 2011 | Iran | 35 | M | Immunocompetent | Left helix and antihelix | 6 | MA, IM |
| Tarkan et al.6 | 2012 | Turkey | 35 | M | Immunocompetent | Right helix and pinna | - | MA, 15mg/kg/d IM for 15 d |
Abbreviations: F, female; IM, intramuscular; M, male; MA, meglumine antimoniate.
The cases of CL affecting the ear lobe described here involved elderly (73 and 86 years of age), immunocompetent patients from rural populations. The clinical features of the first patient were a torpid infiltrated plaque with ulceration and crusting that had appeared more than 6 months earlier. The second patient presented with a nodule that had developed shortly beforehand. The clinical course of the cases described in Table 1 ranged from 2 to 16 months. Diagnosis was delayed due to the atypical presentation, and was usually established only after several medical visits. Treatment in most cases was with intramuscular pentavalent antimonials, given the tendency towards chronicity and the risk of deformity at the site of the lesion, although intralesional administration can also bring about complete resolution of the lesion.
The differential diagnosis of ulcerative lesions of the ear is broad, and includes acute lesions (eg, infections, Winkler disease, bites, sarcoidosis, granulomas, and neoplasms) and chronic lesions (eg, lupus vulgaris, discoid lupus, leprosy, and lymphoma).1–4,6–10 Clinical history is very important for diagnosis, which should be confirmed by microbiological studies and molecular biology techniques.4
Old World CL usually heals spontaneously within 3 to 18 months, leaving a scar.1,6 Treatment is indicated in cases that involve multiple or large lesions, persist for more than 6 months (chronic CL), or affect regions at risk of functional or aesthetic compromise, such as the ear lobe.3,6 Localized forms are treated using local treatments such as intralesional MA (Case 2), the efficacy of which can be very high, albeit variable.1,2,6 The treatment of choice for chronic forms is parenteral pentavalent antimonials,3 which can be complemented with local treatments such as cryotherapy, as described in Case 1.
Rapid recognition of this disease can permit earlier treatment, decreasing the likelihood of the development of residual lesions.
Please cite this article as: Blasco Morente G, Rodríguez-Granger J, Tercedor Sánchez J, Latorre Fuentes JM. Infección del lóbulo auricular por Leishmania en el Viejo Mundo: una localización excepcional. Actas Dermosifiliogr. 2014;105:628–630.